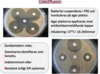

Antibiotikaresistensbestämning Flashcards
(34 cards)
Skillnad på smalt spektrum och bred spektrum vad gäller antibiotika?

Baktericid?
bakterieavdödande- bakterien dör helt
Bakteriostatisk?
bakteriehämmande- hämmar tillväxt av bakterier men kräver att immunsystemet kan ta hand om de bakterier som överlever
Perorala antibiotika?
ges i tablettform , lätta att administreras
Intravenösa antibiotika?
kräver ofta sjukhus, inneliggande patienter
Ge exempel på gram- och gram+ kocker och stavar

Det finns 2 typ av antibiotikaresistens, vilka är de och hur skiljer dem sig åt?

Varför uppstår antibiotikaresistens?
Selektionstryck pga antibiotikaanvändande inom
- Humanmedicin
- Veterinärmedicin
- Djuruppfödning (tillväxtfaktorer)
• Jordbruk
Varför persisterar antibiotikaresistens?
• resistensgener selekteras tillsammans med andra gener
- kompensatoriska mutationer ger minskad ”kostnad”
- ekologiska fördelar för resistenta bakterier?
Antibiotikaresistens bestämning kan göras med:
Kirby-Bauer, Disk diffusion
Platt och rör spädning
MIC bestämning
Automatiserade instrument
PCR
Berätta om diskdiffusion
Vad menas med MIC? hur kan du få fram ett MIC-värde?

För att få fram mic-värde kan man använda sig av plattbuljongmetoder. beskriv detta

Med hjälp av E-test kan du få fram ett MIC-värde, hur fungerar detta test

Beskriv klassificering av antibiotikaresistens med SIR-systemet

När används PCR inom antibiotikaresistensbestämning

Vid användning av resistensbestämning enligt EUCAST lappdiffusionsmetod
Vilket medie?
- Använd endast Mueller Hintonagar (MH)
- För krävande organismer tillsätts defibrinerat hästblod, NAD
Hur går du tillväga vid inockulering av platta inför diskdiffussions metoden?
När du inkuberar plattorna inom 15 minuter från att antibiotikalapparna har applicerats förhindras någonting. Vadå?
Detta förhindrar prediffusion, vilket annars kan resultera i för stora zoner.

Man ska inkubera plattorna i så små staplar som möjligt för att undvika?
ojämn uppvärmning, vilket kan påverka zonstorlekarna (beroende på inkubatorns effektivitet).
Hur ska du tänka när du undersöker plattor efter inkubering
- Växten ska vara konfluerande.
- Det är viktigt att växten är jämn för att få fina zonkanter (se exempel på nästa bild).
- Om enskilda kolonier syns är inokulatet för tunt och resistensbestämningen måste göras om.
Hur läser du av din platta?


Vad finns de för felkällor vid användandet av antibiotikalappar
Prediffusion och ojämn uppvärmning -> felaktiga zoner

Detektion med diskdiffussions-resistensbestämning
- MRSA
- VRE
- ESBL
- Carbapenaser
Vanlig diskdiffusions-resistensbestämning; Screening antibiotika
- *MRSA** – tex oxacillin, cefoxitin (FOX)
- *VRE** – vancomycin
- *ESBL** tex cefadroxil, cefotaxime
- *Carbapenemaser** - meropenem eller imepenem
Går vidare med fenotypiska och genotypiska tester tex DDT, PCR mm
Resistensbestämning MRSA







